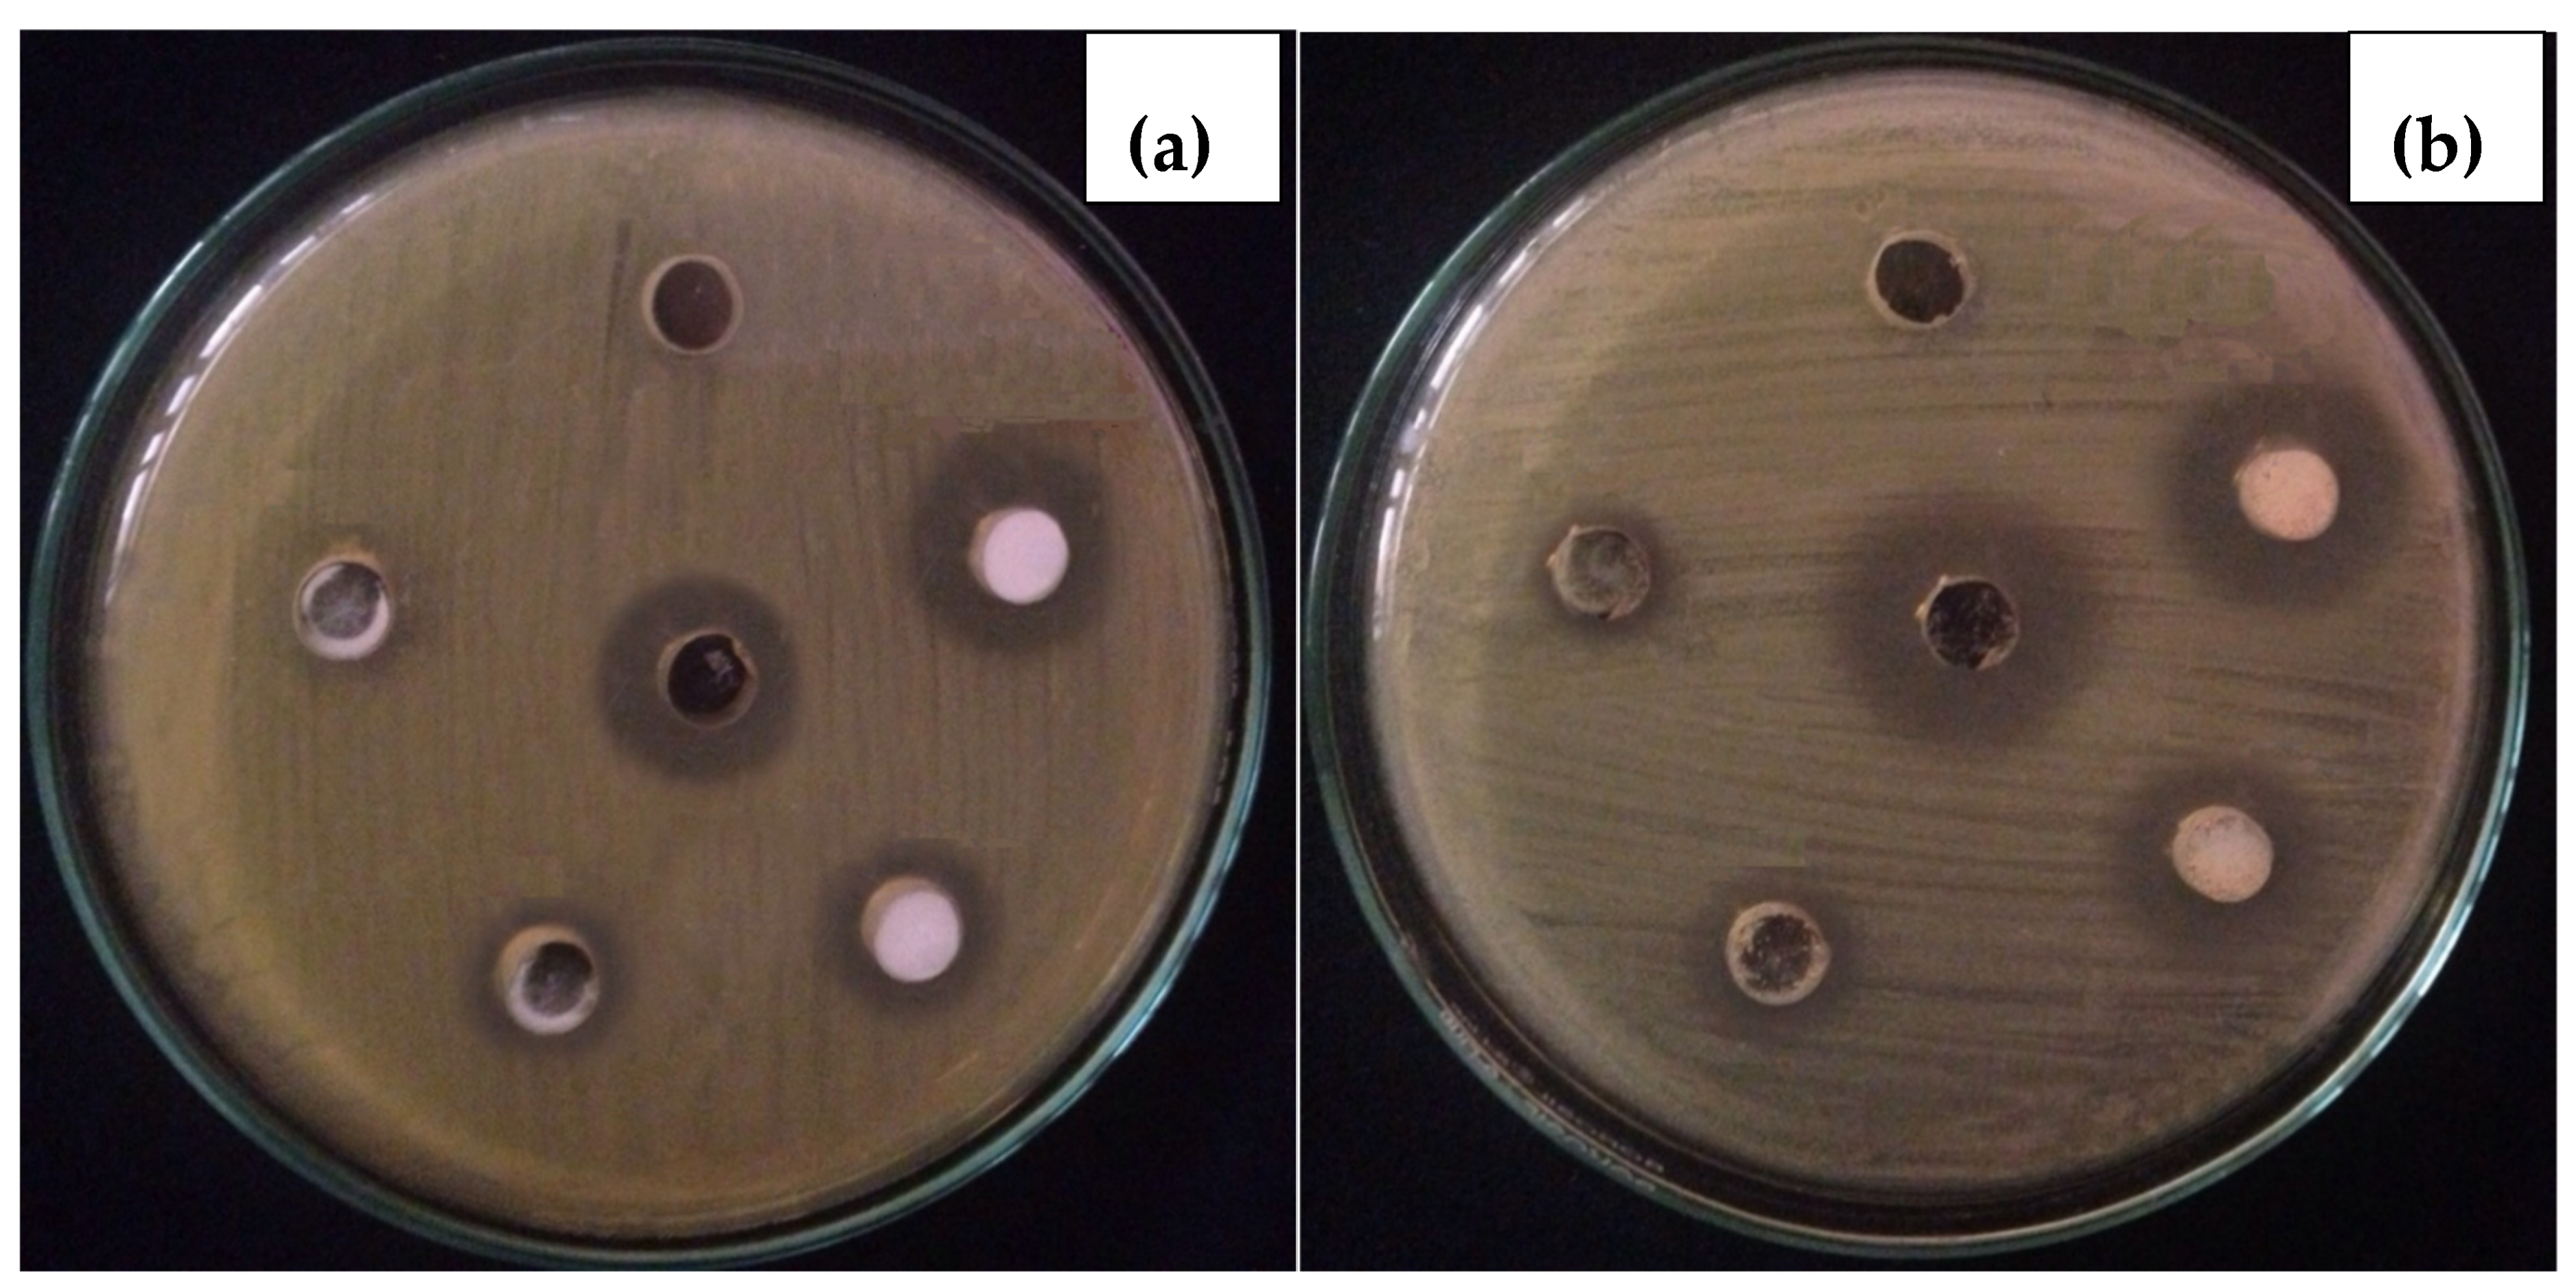
Toxics 09 00105 g005 Toxics 09 00105 g005

In-Vitro and In-Vivo Tolerance and Therapeutic Investigations of Phyto-Fabricated Iron Oxide Nanoparticles against Selected Pathogens
Abstract
1. Introduction
2. Materials and Methods
2.1. Chemical Used
2.2. Preparation of P. emodi Leaves Extract
2.3. Synthesis of Fe2O3 NPs
2.4. Characterization
2.5. Minimum Inhibitory Concentration Assay
2.6. In-Vitro Antibacterial Assay
2.7. Tolerance Study
2.8. In-Vivo Antibacterial Study
2.9. Histopathological Study
2.10. Hematological Assay
3. Results
3.1. Physicochemical Study
3.1.1. Surface Area and XRD Analysis
3.1.2. SEM and TEM Analysis
3.1.3. FTIR and EDX Analysis
3.2. In-Vitro Therapeutic Study
3.2.1. Minimum Inhibitory Concentration
3.2.2. In-Vitro Antibacterial Activity
3.3. Tolerance and Therapeutic Study
3.3.1. Histopathological Analysis
3.3.2. Hematological Analysis
4. Conclusions
Author Contributions
Funding
Institutional Review Board Statement
Informed Consent Statement
Acknowledgments
Conflicts of Interest
References
- Zare, E.; Pourseyedi, S.; Khatami, M.; Darezereshki, E. Simple biosynthesis of zinc oxide nanoparticles using nature’s source, and it’s in vitro bio-activity. J. Mol. Struct. 2017, 1146, 96–103. [Google Scholar] [CrossRef]
- Haq, S.; Rehman, W.; Waseem, M.; Meynen, V.; Awan, S.U.; Saeed, S.; Iqbal, N. Fabrication of pure and moxifloxacin functionalized silver oxide nanoparticles for photocatalytic and antimicrobial activity. J. Photochem. Photobiol. B Biol. 2018, 186, 116–124. [Google Scholar] [CrossRef] [PubMed]
- Haq, S.; Rehman, W.; Waseem, M.; Shah, A.; Khan, A.R. Green synthesis and characterization of tin dioxide nanoparticles for photocatalytic and antimicrobial studies. Mater. Res. Express 2020, 7, 1–9. [Google Scholar] [CrossRef]
- Shah, A.; Haq, S.; Rehman, W.; Waseem, M.; Shoukat, S.; Rehman, M.U. Photocatalytic and antibacterial activities of paeonia emodi mediated silver oxide nanoparticles. Mater. Res. Express 2019, 6, 1–8. [Google Scholar] [CrossRef]
- Bhattacharya, R.; Mukherjee, P. Biological properties of “naked” metal nanoparticles. Adv. Drug Deliv. Rev. 2008, 60, 1289–1306. [Google Scholar] [CrossRef] [PubMed]
- Parveen, S.; Misra, R.; Sahoo, S.K. Nanoparticles: A boon to drug delivery, therapeutics, diagnostics and imaging. Nanomed. Nanotechnol. Biol. Med. 2012, 8, 147–166. [Google Scholar] [CrossRef]
- Iv, M.; Telischak, N.; Feng, D.; Holdsworth, S.; Yeom, K.; Daldrup-Link, H. Clinical applications of iron oxide nanoparticles for magnetic resonance imaging of brain tumors. Nanomedicine 2015, 10, 993–1018. [Google Scholar] [CrossRef]
- Espinosa, A.; Di Corato, R.; Kolosnjaj-Tabi, J.; Flaud, P.; Pellegrino, T.; Wilhelm, C. Duality of Iron Oxide Nanoparticles in Cancer Therapy: Amplification of Heating Efficiency by Magnetic Hyperthermia and Photothermal Bimodal Treatment. ACS Nano 2016, 10, 2436–2446. [Google Scholar] [CrossRef]
- Alexiou, C.; Schmid, R.J.; Jurgons, R.; Kremer, M.; Wanner, G.; Bergemann, C.; Huenges, E.; Nawroth, T.; Arnold, W.; Parak, F.G. Targeting cancer cells: Magnetic nanoparticles as drug carriers. Eur. Biophys. J. 2006, 35, 446–450. [Google Scholar] [CrossRef]
- Kamran, M.; Ali, H.; Saeed, M.F.; Bakhat, H.F.; Hassan, Z.; Tahir, M.; Abbas, G.; Naeem, M.A.; Rashid, M.I.; Shah, G.M. Unraveling the toxic effects of iron oxide nanoparticles on nitrogen cycling through manure-soil-plant continuum. Ecotoxicol. Environ. Saf. 2020, 205, 111099. [Google Scholar] [CrossRef]
- Yarjanli, Z.; Ghaedi, K.; Esmaeili, A.; Rahgozar, S.; Zarrabi, A. Iron oxide nanoparticles may damage to the neural tissue through iron accumulation, oxidative stress, and protein aggregation. BMC Neurosci. 2017, 18, 1–12. [Google Scholar] [CrossRef]
- Szalay, B.; Tátrai, E. Potential toxic effects of iron oxide nanoparticles in in vivo and in vitro experiments. J. Appl. Toxicol. 2012, 446–453. [Google Scholar] [CrossRef]
- Askri, D.; Cunin, V.; Béal, D.; Berthier, S.; Chovelon, B.; Arnaud, J.; Rachidi, W.; Sakly, M.; Amara, S.; Sève, M.; et al. Investigating the toxic effects induced by iron oxide nanoparticles on neuroblastoma cell line: An integrative study combining cytotoxic, genotoxic and proteomic tools. Nanotoxicology 2019, 13, 1021–1040. [Google Scholar] [CrossRef] [PubMed]
- Ahmad, S.; Farrukh, M.A.; Khan, M.; Khaleeq-ur-, M.; Tahir, M.A. Synthesis of Iron Oxide–Tin Oxide Nanoparticles and Evaluation of their Activities against Different Bacterial Strains. Can. Chem. Trans. 2014, 2, 122–133. [Google Scholar] [CrossRef]
- Guardia, P.; Labarta, A.; Batlle, X. Tuning the Size, the Shape, and the Magnetic Properties of Iron Oxide Nanoparticles. J. Phys. Chem. C 2011, 115, 390–396. [Google Scholar] [CrossRef]
- Bhuiyan, M.S.H.; Miah, M.Y.; Paul, S.C.; Aka, T.D.; Saha, O.; Rahaman, M.M.; Sharif, M.J.I.; Habiba, O.; Ashaduzzaman, M. Green synthesis of iron oxide nanoparticle using Carica papaya leaf extract: Application for photocatalytic degradation of remazol yellow RR dye and antibacterial activity. Heliyon 2020, 6, e04603. [Google Scholar] [CrossRef] [PubMed]
- Jasper, R.; Locatelli, G.O.; Pilati, C.; Locatelli, C. Evaluation of biochemical, hematological and oxidative parameters in mice exposed to the herbicide glyphosate-roundup®. Interdiscip. Toxicol. 2012, 5, 133–140. [Google Scholar] [CrossRef]
- Gad, S.B.; Zaghloul, D.M. Beneficial effects of green tea extract on liver and kidney functions, ultrastructure, lipid profile and hematological parameters in aged male rats. Glob. Vet. 2013, 11, 191–205. [Google Scholar] [CrossRef]
- Wang, D.; Li, H.; Liu, Z.; Zhou, J.; Zhang, T. Acute toxicological effects of zinc oxide nanoparticles in mice after intratracheal instillation. Int. J. Occup. Environ. Health 2017, 23, 11–19. [Google Scholar] [CrossRef]
- Gao, L.; Yang, S.T.; Li, S.; Meng, Y.; Wang, H.; Lei, H. Acute toxicity of zinc oxide nanoparticles to the rat olfactory system after intranasal instillation. J. Appl. Toxicol. 2013, 33, 1079–1088. [Google Scholar] [CrossRef]
- Chen, J.; Li, C.; Guan, Y.; Kong, Q.; Li, C.; Guo, X.; Chen, Q.; Jing, X.; Lv, Z.; An, Y. Protection of mice from lethal Escherichia coli infection by chimeric human bactericidal/permeability-increasing protein and immunoglobulin G1 Fc gene delivery. Antimicrob. Agents Chemother. 2007, 51, 724–731. [Google Scholar] [CrossRef]
- Llobet, J.M.; Domingo, J.L.; Colomina, M.T.; Mayayo, E.; Corbella, J. Subchronic oral toxicity of zinc in rats. Bull. Environ. Contam. Toxicol. 1988, 41, 36–43. [Google Scholar] [CrossRef]
- Hunter, P.A.; Rolinson, G.N.; Witting, D.A. Comparative activity of amoxycillin and ampicillin in an experimental bacterial infection in mice. Antimicrob. Agents Chemother. 1973, 4, 285–293. [Google Scholar] [CrossRef][Green Version]
- Al-Qayim, A.J.M.; Ghali, L.; Al-Azwai, T. Comparative effects of propolis and malic acid on hematological parameters of aluminum exposed male rats. Glob. J. Biosci. Biotechnol. 2014, 3, 6–11. [Google Scholar]
- Shanker, K.; Mohan, G.K.; Hussain, M.A.M.; Jayarambabu, N.; Pravallika, P.L. Green Biosynthesis, Characterization, In vitro Antidiabetic Activity, and Investigational Acute Toxicity Studies of Some Herbal-mediated Silver Nanoparticles on Animal Models. Phcog. Mag. 2017, 13, 188–192. [Google Scholar] [CrossRef]
- Jeng, H.A.; Swanson, J. Toxicity of Metal Oxide Nanoparticles in Mammalian Cells. J. Environ. Sci. Health Part A 2006, 41, 2699–2711. [Google Scholar] [CrossRef]
- Akah, P.; Alemji, J. Studies on the effects of Vernonia amygdalina leaf extract and fractions on biochemical and hematological parameters in diabetic rats. Planta Med. 2009, 75. [Google Scholar] [CrossRef]
- Rodrigues, J.M.; Fessi, H.; Bories, C.; Puisieux, F.; Devissaguet, J. Primaquine-loaded poly(lactide) nanoparticles: Physicochemical study and acute tolerance in mice. Int. J. Pharm. 1995, 126, 253–260. [Google Scholar] [CrossRef]
- Kelly Nitsche, E. Erythrocytosis in Dogs and Cats: Diagnosis and Management. Compend. Contin. Educ. Pract. Vet. 2004, 26, 104–121. [Google Scholar]
- Teeguarden, J.G.; Hinderliter, P.M.; Orr, G.; Thrall, B.D.; Pounds, J.G. Particokinetics in vitro: Dosimetry considerations for in vitro nanoparticle toxicity assessments. Toxicol. Sci. 2007, 95, 300–312. [Google Scholar] [CrossRef] [PubMed]
- Hein, M.S. Copper deficiency anemia and nephrosis in zinc-toxicity: A case report. South Dak. J. Med. 2003, 56, 143–147. [Google Scholar]

| Parameters | E. coli Infected Mice | E. coli-Fe2O3 Inoculated Mice | S. aureus Infected Mice | S. aureus-Fe2O3 Inoculated Mice | Normal Range |
|---|---|---|---|---|---|
| WBC | 13.7 × 109/L | 1.7 × 109/L | 8.8 × 109/L | 2.9 × 109/L | 0.8–6.8 |
| Lymph # | 4.2 × 109/L | 1.2 × 109/L | 4.7 × 109/L | 2.3 × 109/L | 0.7–5.7 |
| Mon # | 1.2 × 109/L | 0.1 × 109/L | 0.6 × 109/L | 0.1 × 109/L | 0.0–0.3 |
| Gran # | 8.4 × 109/L | 0.4 × 109/L | 3.5 × 109/L | 0.5 × 109/L | 0.1–1.8 |
| Lymph % | 30.0% | 71.5% | 53.0% | 79.8% | 55.8–90.6 |
| Mon % | 8.8% | 3.0% | 7.7% | 3.2% | 1.8–6.0 |
| Gran % | 61.1% | 25.5% | 39.7% | 17.0% | 6.36–9.42 |
| RBC | 9.24 × 1012/L | 7.02 × 1012/L | 8.45 × 1012/L | 8.61 × 1012/L | 11.0–14.3 |
| HGB | 11.1 g/dL | 10.9 g/dL | 13.2 g/dL | 11.8 g/dL | 8.6–38.9 |
| HCT | 39.6% | 37.3% | 44.9% | 42.0% | 34.6–44.0 |
| MCV | 42.9 fL (L) | 53.2 fL (L) | 53.0 fL | 48.8 fL (L) | 48.2–58.3 |
| MCH | 12.0 pg (L) | 15.5 pg (L) | 15.5 pg (L) | 13.7 pg (L) | 15.8–19.0 |
| MCHC | 28.0 g/dL (L) | 29.2 g/dL (L) | 29.3 g/dL (L) | 28.0 g/dL (L) | 30.2–35.3 |
| RDW | 20.3% (H) | 17.5% (H) | 21.1% (H) | 16.3% (H) | 13.0–17.0 |
| PLT | 2599 × 109/L (H) | 1119 × 109/L (H) | 1016 × 109/L (H) | 143 × 109/L (H) | 450–1690 |
| MPV | 4.9 fL | 6.0 fL | 5.5 fL | 6.1 fL | 3.8–6.0 |
| PDW | 15.7 | 16.7 | 16.6 | 18.2 | -- |
| PCT | -- | 0.671 | 0.558% | 0.087 | -- |
Publisher’s Note: MDPI stays neutral with regard to jurisdictional claims in published maps and institutional affiliations. |
© 2021 by the authors. Licensee MDPI, Basel, Switzerland. This article is an open access article distributed under the terms and conditions of the Creative Commons Attribution (CC BY) license (https://creativecommons.org/licenses/by/4.0/).
Share and Cite
Shah, A.; Tauseef, I.; Ali, M.B.; Yameen, M.A.; Mezni, A.; Hedfi, A.; Haleem, S.K.; Haq, S. In-Vitro and In-Vivo Tolerance and Therapeutic Investigations of Phyto-Fabricated Iron Oxide Nanoparticles against Selected Pathogens. Toxics 2021, 9, 105. https://doi.org/10.3390/toxics9050105
Shah A, Tauseef I, Ali MB, Yameen MA, Mezni A, Hedfi A, Haleem SK, Haq S. In-Vitro and In-Vivo Tolerance and Therapeutic Investigations of Phyto-Fabricated Iron Oxide Nanoparticles against Selected Pathogens. Toxics. 2021; 9(5):105. https://doi.org/10.3390/toxics9050105
Chicago/Turabian StyleShah, Amreen, Isfahan Tauseef, Manel Ben Ali, Muhammad Arfat Yameen, Amine Mezni, Amor Hedfi, Syed Kashif Haleem, and Sirajul Haq. 2021. "In-Vitro and In-Vivo Tolerance and Therapeutic Investigations of Phyto-Fabricated Iron Oxide Nanoparticles against Selected Pathogens" Toxics 9, no. 5: 105. https://doi.org/10.3390/toxics9050105
APA StyleShah, A., Tauseef, I., Ali, M. B., Yameen, M. A., Mezni, A., Hedfi, A., Haleem, S. K., & Haq, S. (2021). In-Vitro and In-Vivo Tolerance and Therapeutic Investigations of Phyto-Fabricated Iron Oxide Nanoparticles against Selected Pathogens. Toxics, 9(5), 105. https://doi.org/10.3390/toxics9050105

